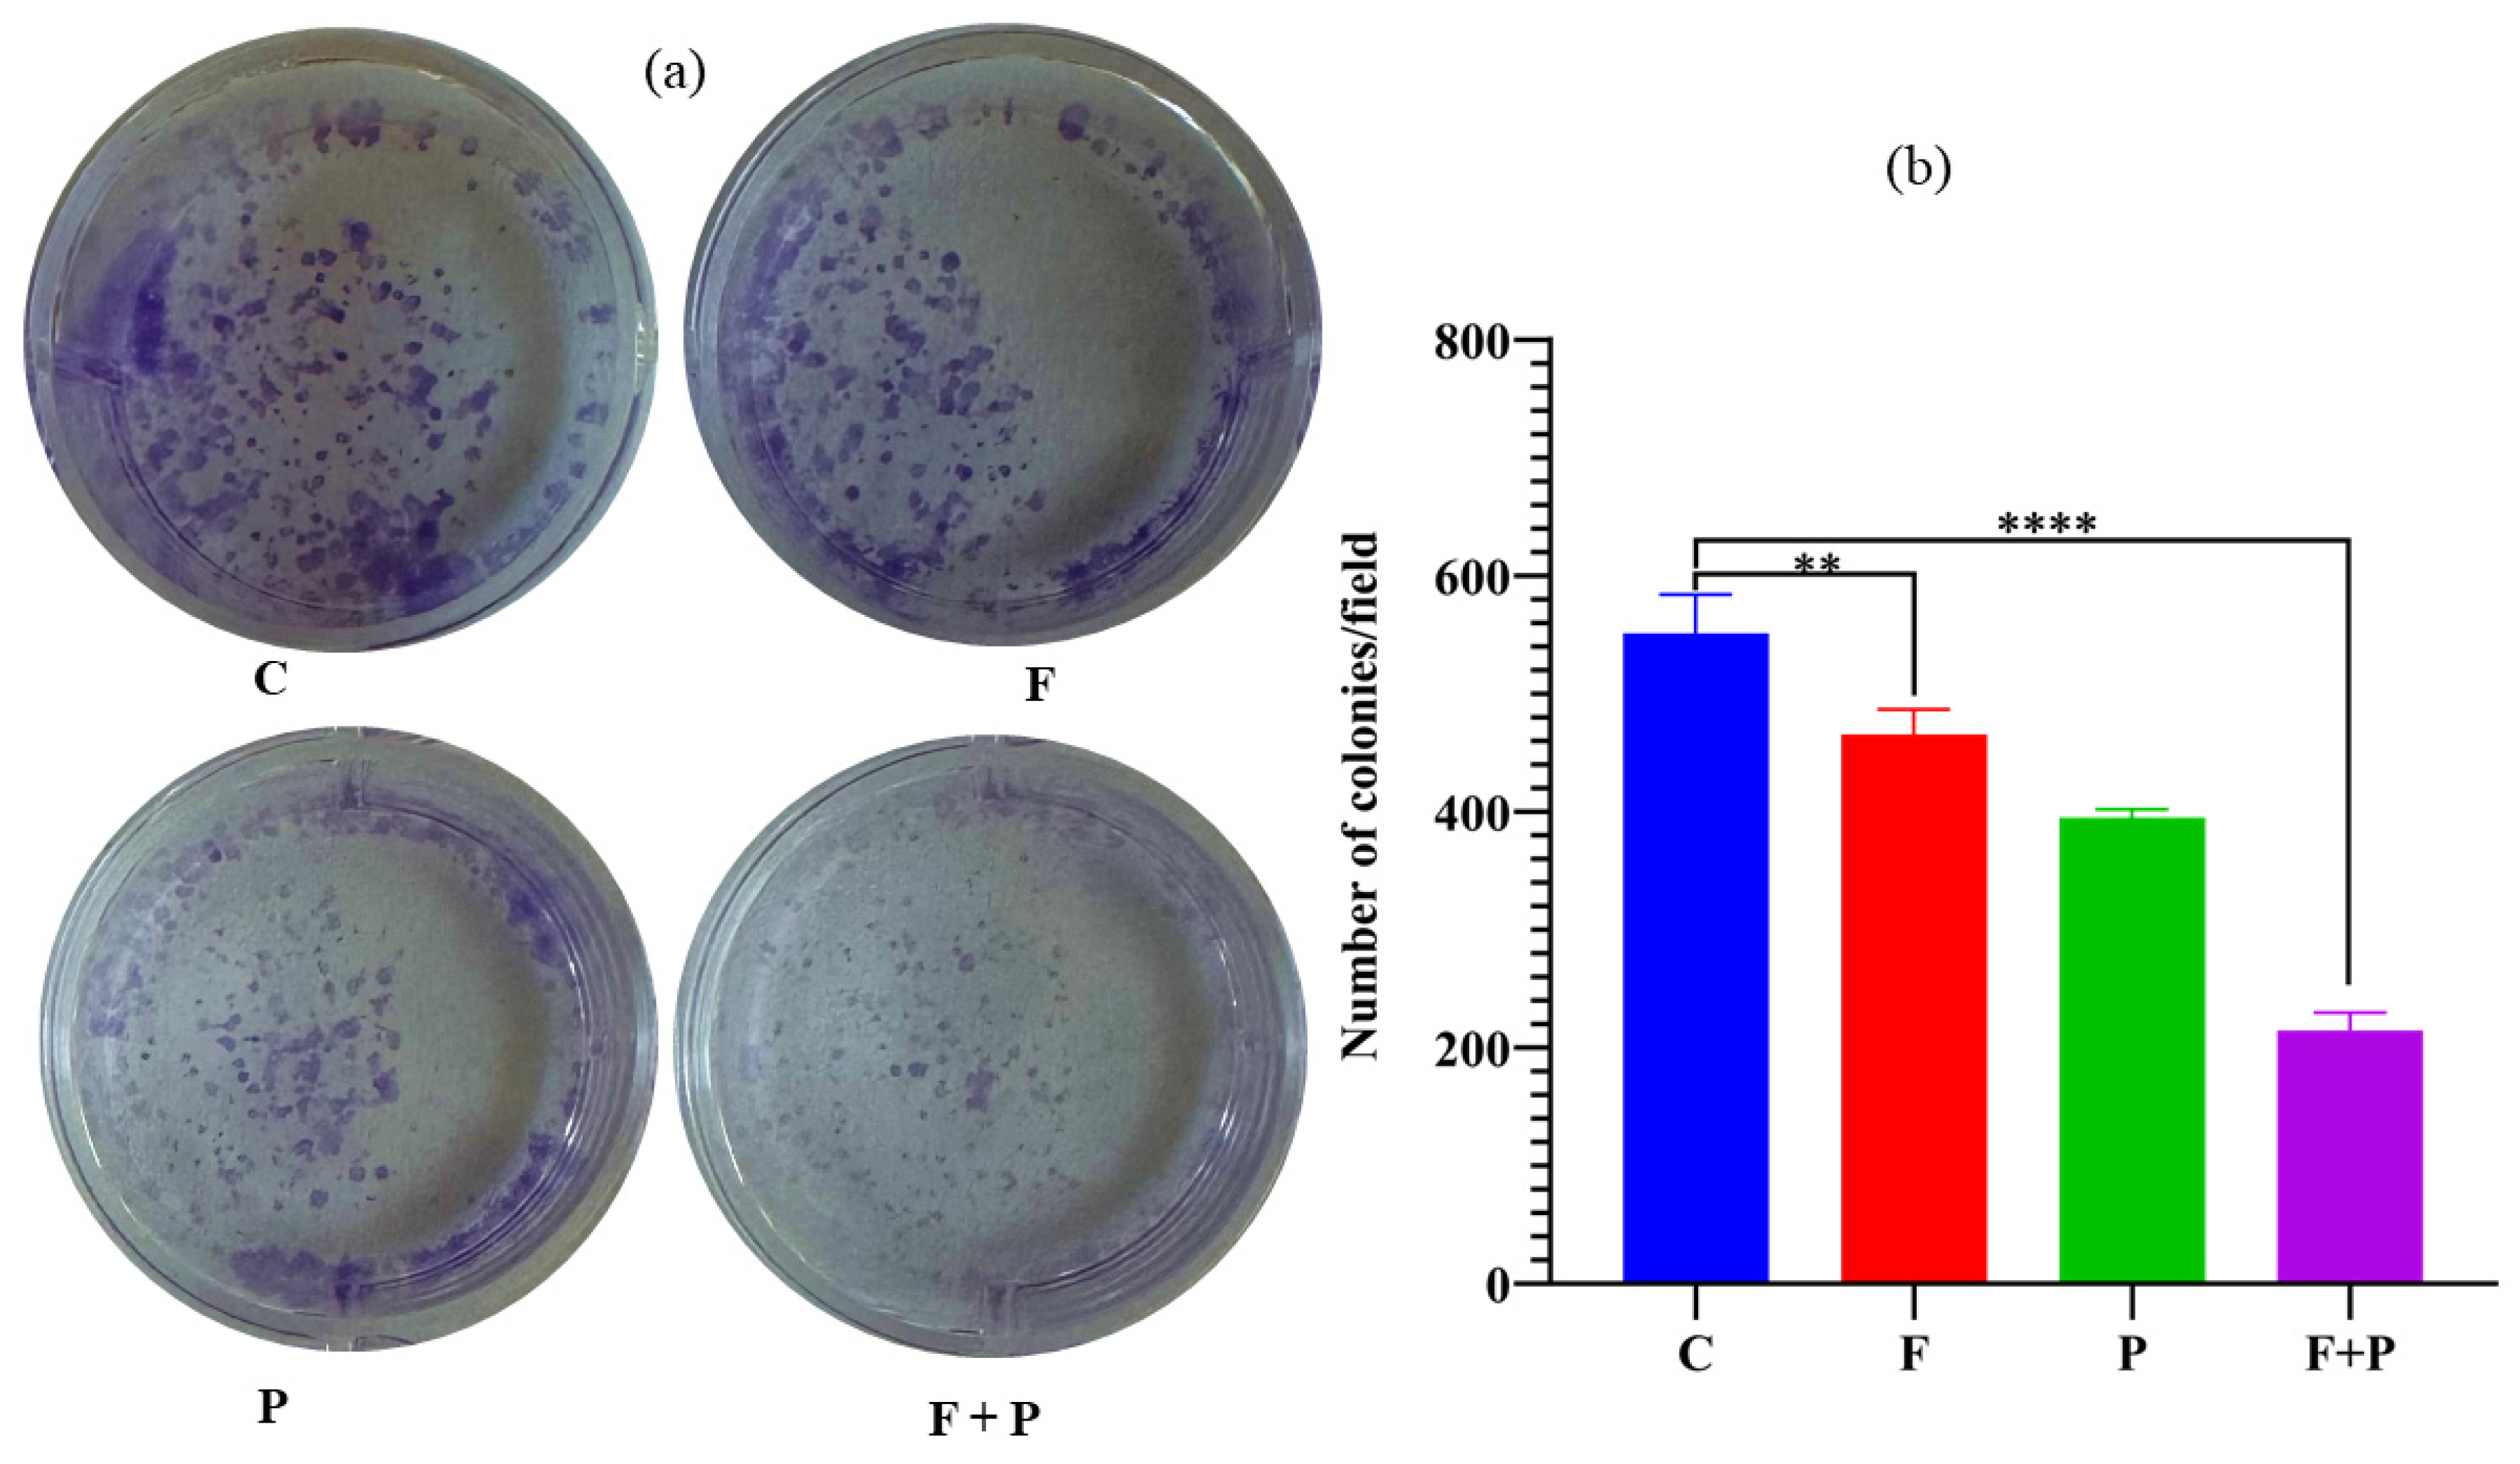
Pharmaceuticals 17 00327 g009

Evaluation of Antiproliferative Properties of CoMnZn-Fe2O4 Ferrite Nanoparticles in Colorectal Cancer Cells
Abstract
1. Introduction
2. Results and Discussion
2.1. XRD
2.2. TEM Image of X2 Nanoparticles
2.3. Raman Spectra of X1, X2, and X3 Nanoparticles
2.4. DLS, FTIR, and XPS of X1, X2, and X3 Nanoparticles
2.5. Magnetic Characterization of Nanoparticles
2.6. Magnetic Hyperthermia of Co,Mn,Zn-Fe2O4 Nanoparticles in Water and Agar Ferrogel
2.7. MTT Cytotoxicity Assay
2.8. Apoptosis Assay
2.9. Colony Formation Assay of HCT116 Cells Treated with AMF
2.10. Wound Healing Assay of HCT116 Cells Treated with AMF
3. Materials and Methods
3.1. Synthesis of Co, Mn, and Zn-Fe2O4 Nanoparticles
3.2. Characterization of the Nanoparticles
3.3. Magneto-Thermal Measurements
3.4. MTT Assay
3.5. Apoptosis Assay Using Flow Cytometry
3.6. In Vitro Wound Healing Assay
3.7. Cell Colony Formation Assay
3.8. Statistical Analysis
4. Conclusions
Supplementary Materials
Author Contributions
Funding
Institutional Review Board Statement
Informed Consent Statement
Data Availability Statement
Acknowledgments
Conflicts of Interest
References
- Liu, X.; Zhang, Y.; Wang, Y.; Zhu, W.; Li, G.; Ma, X.; Zhang, Y.; Chen, S.; Tiwari, S.; Shi, K.; et al. Comprehensive Understanding of Magnetic Hyperthermia for Improving Antitumor Therapeutic Efficacy. Theranostics 2020, 10, 3793–3815. [Google Scholar] [CrossRef]
- Su, D.; Wu, K.; Saha, R.; Peng, C.; Wang, J.-P. Advances in Magnetoresistive Biosensors. Micromachines 2019, 11, 34. [Google Scholar] [CrossRef] [PubMed]
- Price, P.M.; Mahmoud, W.E.; Al-Ghamdi, A.A.; Bronstein, L.M. Magnetic Drug Delivery: Where the Field Is Going. Front. Chem. 2018, 6, 619. [Google Scholar] [CrossRef] [PubMed]
- Chang, D.; Lim, M.; Goos, J.A.C.M.; Qiao, R.; Ng, Y.Y.; Mansfeld, F.M.; Jackson, M.; Davis, T.P.; Kavallaris, M. Biologically Targeted Magnetic Hyperthermia: Potential and Limitations. Front. Pharmacol. 2018, 9, 831. [Google Scholar] [CrossRef] [PubMed]
- Cardoso, V.F.; Francesko, A.; Ribeiro, C.; Bañobre-López, M.; Martins, P.; Lanceros-Mendez, S. Advances in Magnetic Nanoparticles for Biomedical Applications. Adv. Healthc. Mater. 2018, 7, 1700845. [Google Scholar] [CrossRef] [PubMed]
- Rajan, A.; Sahu, N.K. Review on Magnetic Nanoparticle-Mediated Hyperthermia for Cancer Therapy. J. Nanopart. Res. 2020, 22, 319. [Google Scholar] [CrossRef]
- Xiao, Y.; Du, J. Superparamagnetic Nanoparticles for Biomedical Applications. J. Mater. Chem. B 2020, 8, 354–367. [Google Scholar] [CrossRef] [PubMed]
- Abenojar, E.C.; Wickramasinghe, S.; Bas-Concepcion, J.; Samia, A.C.S. Structural Effects on the Magnetic Hyperthermia Properties of Iron Oxide Nanoparticles. Prog. Nat. Sci. Mater. Int. 2016, 26, 440–448. [Google Scholar] [CrossRef]
- Obaidat, I.M.; Issa, B.; Haik, Y. Magnetic Properties of Magnetic Nanoparticles for Efficient Hyperthermia. Nanomaterials 2015, 5, 63–89. [Google Scholar] [CrossRef]
- Pardo, A.; Yáñez, S.; Piñeiro, Y.; Iglesias-Rey, R.; Al-Modlej, A.; Barbosa, S.; Rivas, J.; Taboada, P. Cubic Anisotropic Co- and Zn-Substituted Ferrite Nanoparticles as Multimodal Magnetic Agents. ACS Appl. Mater. Interfaces 2020, 12, 9017–9031. [Google Scholar] [CrossRef]
- Narayanaswamy, V.; Al-Omari, I.A.; Kamzin, A.S.; Issa, B.; Tekin, H.O.; Khourshid, H.; Kumar, H.; Mallya, A.; Sambasivam, S.; Obaidat, I.M. Specific Absorption Rate Dependency on the Co2+ Distribution and Magnetic Properties in CoxMn1-XFe2O4 Nanoparticles. Nanomaterials 2021, 11, 1231. [Google Scholar] [CrossRef] [PubMed]
- Singh, A.; Kumar, P.; Pathak, S.; Jain, K.; Garg, P.; Pant, M.; Mahapatro, A.K.; Rath, D.; Wang, L.; Kim, S.-K.; et al. A Threefold Increase in SAR Performance for Magnetic Hyperthermia by Compositional Tuning in Zinc-Substituted Iron Oxide Superparamagnetic Nanoparticles with Superior Biocompatibility. J. Alloys Compd. 2023, 968, 171868. [Google Scholar] [CrossRef]
- Beola, L.; Asín, L.; Roma-Rodrigues, C.; Fernández-Afonso, Y.; Fratila, R.M.; Serantes, D.; Ruta, S.; Chantrell, R.W.; Fernandes, A.R.; Baptista, P.V.; et al. The Intracellular Number of Magnetic Nanoparticles Modulates the Apoptotic Death Pathway after Magnetic Hyperthermia Treatment. ACS Appl. Mater. Interfaces 2020, 12, 43474–43487. [Google Scholar] [CrossRef] [PubMed]
- Yoo, D.; Jeong, H.; Preihs, C.; Choi, J.; Shin, T.-H.; Sessler, J.L.; Cheon, J. Double-Effector Nanoparticles: A Synergistic Approach to Apoptotic Hyperthermia. Angew. Chem. 2012, 124, 12650–12653. [Google Scholar] [CrossRef]
- Giustini, A.J.; Petryk, A.A.; Cassim, S.M.; Tate, J.A.; Baker, I.; Hoopes, P.J. Magnetic Nanoparticle Hyperthermia in Cancer Treatment. Nano Life 2010, 1, 17–32. [Google Scholar] [CrossRef] [PubMed]
- Crezee, J.; Franken, N.; Oei, A. Hyperthermia-Based Anti-Cancer Treatments. Cancers 2021, 13, 1240. [Google Scholar] [CrossRef]
- Singh, A.; Jain, S.; Sahoo, S.K. Magnetic Nanoparticles for Amalgamation of Magnetic Hyperthermia and Chemotherapy: An Approach towards Enhanced Attenuation of Tumor. Mater. Sci. Eng. C 2020, 110, 110695. [Google Scholar] [CrossRef]
- Kauanova, S.; Urazbayev, A.; Vorobjev, I. The Frequent Sampling of Wound Scratch Assay Reveals the “Opportunity” Window for Quantitative Evaluation of Cell Motility-Impeding Drugs. Front. Cell Dev. Biol. 2021, 9, 640972. [Google Scholar] [CrossRef]
- Rajendran, V.; Jain, M.V. In Vitro Tumorigenic Assay: Colony Forming Assay for Cancer Stem Cells. Methods Mol. Biol. 2018, 1692, 89–95. [Google Scholar]
- Jain, R. A Review on the Development of XRD in Ferrite Nanoparticles. J. Supercond. Nov. Magn. 2022, 35, 1033–1047. [Google Scholar] [CrossRef]
- Kamzin, A.S.; Semenov, V.G.; Al-Omari, I.A.; Narayanaswamy, V.; Issa, B. Magnetic structure of Co0.8-xMnxZn0.2Fe2O4 nanoparticles (x = 0.6, 0.4 and 0.2) promising for biomedical applications. Phys. Solid State 2023, 65, 8. [Google Scholar]
- Patterson, A.L. The Scherrer Formula for X-Ray Particle Size Determination. Phys. Rev. 1939, 56, 978–982. [Google Scholar] [CrossRef]
- Vinosha, P.A.; Mely, L.A.; Jeronsia, J.E.; Krishnan, S.; Das, S.J. Synthesis and Properties of Spinel ZnFe2O4 Nanoparticles by Facile Co-Precipitation Route. Optik 2017, 134, 99–108. [Google Scholar] [CrossRef]
- Obaidat, I.M.; Mohite, V.; Issa, B.; Tit, N.; Haik, Y. Predicting a Major Role of Surface Spins in the Magnetic Properties of Ferrite Nanoparticles. Cryst. Res. Technol. 2009, 44, 489–494. [Google Scholar] [CrossRef]
- Issa, B.; Qadri, S.; Obaidat, I.M.; Bowtell, R.W.; Haik, Y. PEG Coating Reduces NMR Relaxivity of Mn0.5 Zn0.5 Gd0.02 Fe1.98 O4 Hyperthermia Nanoparticles. J. Magn. Reson. Imaging 2011, 34, 1192–1198. [Google Scholar] [CrossRef] [PubMed]
- Testa-Anta, M.; Ramos-Docampo, M.A.; Comesaña-Hermo, M.; Rivas-Murias, B.; Salgueiriño, V. Raman Spectroscopy to Unravel the Magnetic Properties of Iron Oxide Nanocrystals for Bio-Related Applications. Nanoscale Adv. 2019, 1, 2086–2103. [Google Scholar] [CrossRef] [PubMed]
- Singh, A.; Pathak, S.; Kumar, P.; Sharma, P.; Rathi, A.; Basheed, G.A.; Maurya, K.K.; Pant, R.P. Tuning the Magnetocrystalline Anisotropy and Spin Dynamics in CoxZn1−xFe2O4 (0 ≤ x ≤ 1) Nanoferrites. J. Magn. Magn. Mater. 2020, 493, 165737. [Google Scholar] [CrossRef]
- Sivaranjani, K.S.; Jacob, G.A.; Joseyphus, R.J. Comprehensive Law-of-Approach-to-Saturation for the Determination of Magnetic Anisotropy in Soft Magnetic Materials. Phys. Status Solidi (B) 2022, 259, 2200050. [Google Scholar] [CrossRef]
- Rosensweig, R.E. Heating Magnetic Fluid with Alternating Magnetic Field. J. Magn. Magn. Mater. 2002, 252, 370–374. [Google Scholar] [CrossRef]
- Baldea, I.; Petran, A.; Florea, A.; Sevastre-Berghian, A.; Nenu, I.; Filip, G.A.; Cenariu, M.; Radu, M.T.; Iacovita, C. Magnetic Nanoclusters Stabilized with Poly[3,4-Dihydroxybenzhydrazide] as Efficient Therapeutic Agents for Cancer Cells Destruction. Nanomaterials 2023, 13, 933. [Google Scholar] [CrossRef]
- Chen, D.; Yu, J.; Zhang, L. Necroptosis: An Alternative Cell Death Program Defending against Cancer. Biochim. Biophys. Acta 2016, 1865, 228–236. [Google Scholar] [CrossRef]
- Seo, J.; Nam, Y.W.; Kim, S.; Oh, D.-B.; Song, J. Necroptosis Molecular Mechanisms: Recent Findings Regarding Novel Necroptosis Regulators. Exp. Mol. Med. 2021, 53, 1007–1017. [Google Scholar] [CrossRef]
- Karakuş, F.; Eyol, E.; Yılmaz, K.; Ünüvar, S. Inhibition of Cell Proliferation, Migration and Colony Formation of LS174T Cells by Carbonic Anhydrase Inhibitor. Afr. Health Sci. 2018, 18, 1303–1310. [Google Scholar] [CrossRef] [PubMed]
- Wang, X.; Decker, C.C.; Zechner, L.; Krstin, S.; Wink, M. In Vitro Wound Healing of Tumor Cells: Inhibition of Cell Migration by Selected Cytotoxic Alkaloids. BMC Pharmacol. Toxicol. 2019, 20, 4. [Google Scholar] [CrossRef] [PubMed]
- Narayanaswamy, V.; Sambasivam, S.; Saj, A.; Alaabed, S.; Issa, B.; Al-Omari, I.A.; Obaidat, I.M. Role of Magnetite Nanoparticles Size and Concentration on Hyperthermia under Various Field Frequencies and Strengths. Molecules 2021, 26, 796. [Google Scholar] [CrossRef] [PubMed]
- Rah, B.; Amin, H.; Yousuf, K.; Khan, S.; Jamwal, G.; Mukherjee, D.; Goswami, A. A Novel MMP-2 Inhibitor 3-Azidowithaferin A (3-AzidoWA) Abrogates Cancer Cell Invasion and Angiogenesis by Modulating Extracellular Par-4. PLoS ONE 2012, 7, e44039. [Google Scholar] [CrossRef]

| Refinement Parameters | X1 | X2 | X3 |
|---|---|---|---|
| Lattice constant (a = b = c) (Å) | 8.3263 | 8.4140 | 8.3865 |
| α = β= γ (°) | 90 | 90 | 90 |
| Density (g/cm3) | 5.705 | 5.528 | 5.583 |
| V (Å3) | 577.2321 | 595.6663 | 589.8453 |
| Bragg R-factor | 2.062 | 1.542 | 2.087 |
| Rf-factor | 1.808 | 1.268 | 1.758 |
| Chi2 | 1.21 | 1.10 | 1.12 |
| Average sizes (nm) | 15.2 | 10.2 | 10.3 |
| Composition | A1g(1) | A1g(2) | T2g(1) | Eg | T2g(3) | IA1g(1)/IA1g(2) |
|---|---|---|---|---|---|---|
| X1 | 605.4 | 468.1 | 284.4 | 166.1 | ||
| X2 | 662.8 | 607.5 | 464.9 | 296.9 | 178.3 | 0.85 |
| X3 | 678.6 | 617.3 | 472.3 | 315.9 | 223.6 | 1.07 |
| Composition | Coercive Field (Oe) | Remnant Magnetization (emu/g) | Ms (emu/g) | Keff (103 Jm−3) | |||
|---|---|---|---|---|---|---|---|
| 5 K | 300 K | 5 K | 300 K | 5 K | 300 K | 300 K | |
| X1 | 4468.6 | 139.8 | 56.18 | 8.12 | 85.99 | 61.23 | 9.52 |
| X2 | 4380.1 | 6.8 | 61.62 | 0.50 | 102.96 | 74.28 | 11.38 |
| X3 | 6382.2 | 7.3 | 60.92 | 0.49 | 94.63 | 69.72 | 10.84 |
| CoCl2.6H2O (g) | MnCl2 (g) | ZnCl2 (g) | FeCl3 (g) | |
|---|---|---|---|---|
| Co0.2Mn0.6Zn0.2Fe2O4 | 0.5094 | 1.2712 | 0.2925 | 3.4728 |
| Co0.4Mn0.4Zn0.2Fe2O4 | 1.0153 | 0.8446 | 0.2915 | 3.4610 |
| Co0.6Mn0.2Zn0.2Fe2O4 | 1.5179 | 0.4208 | 0.2905 | 3.4493 |
Disclaimer/Publisher’s Note: The statements, opinions and data contained in all publications are solely those of the individual author(s) and contributor(s) and not of MDPI and/or the editor(s). MDPI and/or the editor(s) disclaim responsibility for any injury to people or property resulting from any ideas, methods, instructions or products referred to in the content. |
© 2024 by the authors. Licensee MDPI, Basel, Switzerland. This article is an open access article distributed under the terms and conditions of the Creative Commons Attribution (CC BY) license (https://creativecommons.org/licenses/by/4.0/).
Share and Cite
Narayanaswamy, V.; Rah, B.; Al-Omari, I.A.; Kamzin, A.S.; Khurshid, H.; Muhammad, J.S.; Obaidat, I.M.; Issa, B. Evaluation of Antiproliferative Properties of CoMnZn-Fe2O4 Ferrite Nanoparticles in Colorectal Cancer Cells. Pharmaceuticals 2024, 17, 327. https://doi.org/10.3390/ph17030327
Narayanaswamy V, Rah B, Al-Omari IA, Kamzin AS, Khurshid H, Muhammad JS, Obaidat IM, Issa B. Evaluation of Antiproliferative Properties of CoMnZn-Fe2O4 Ferrite Nanoparticles in Colorectal Cancer Cells. Pharmaceuticals. 2024; 17(3):327. https://doi.org/10.3390/ph17030327
Chicago/Turabian StyleNarayanaswamy, Venkatesha, Bilal Rah, Imaddin A. Al-Omari, Alexander S. Kamzin, Hafsa Khurshid, Jibran Sualeh Muhammad, Ihab M. Obaidat, and Bashar Issa. 2024. "Evaluation of Antiproliferative Properties of CoMnZn-Fe2O4 Ferrite Nanoparticles in Colorectal Cancer Cells" Pharmaceuticals 17, no. 3: 327. https://doi.org/10.3390/ph17030327
APA StyleNarayanaswamy, V., Rah, B., Al-Omari, I. A., Kamzin, A. S., Khurshid, H., Muhammad, J. S., Obaidat, I. M., & Issa, B. (2024). Evaluation of Antiproliferative Properties of CoMnZn-Fe2O4 Ferrite Nanoparticles in Colorectal Cancer Cells. Pharmaceuticals, 17(3), 327. https://doi.org/10.3390/ph17030327

